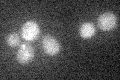
YLR086W
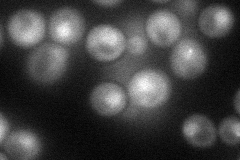
YLR086W
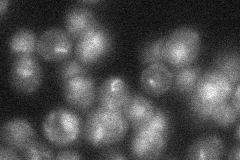
YLR086W

View description
Subunit of the condensin complex; reorganizes chromosomes during cell division; forms a complex with Smc2p that has ATP-hydrolyzing and DNA-binding activity; required for tRNA gene clustering at the nucleolus; potential Cdc28p substrate
Localization:
Intensity:
Fold change:
Significance:
-
C’ GFP library in SD
below threshold15.66 -
N' NOP1pr-GFP in SD
cytosol,nucleus45.8876 -
N' TEF2pr-mCherry in SD

nucleus35.1411 -
N' NATIVEpr-GFP in SD
punctate,nucleus23.9071 -
N' TEF2pr-VC and Cyto-VN in SD

cytosol,nucleus30.415 -
C’ GFP library in SD+DTT

cytosol15.661No -
C’ GFP library in SD+H2O2

cytosol18.241.16No -
C’ GFP library in Starvation Media

cytosol14.650.93No -
C’ GFP library on the background of Pup2-DaMP

below threshold -
C’ GFP library on the background of CCT mutant

below threshold17.61081.12412No
